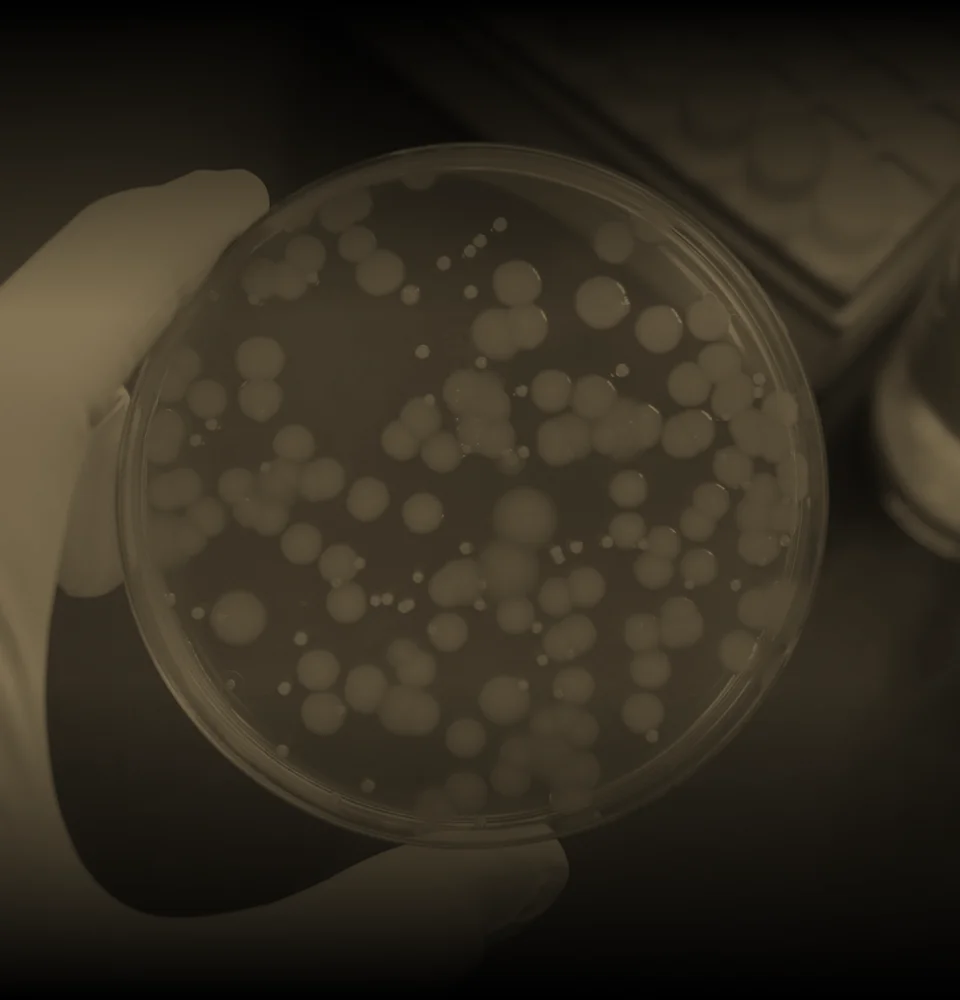

About NAISS

“NAISS — The Origin of Beauty”
NAISS comes from the French "Naissance," symbolizing renewal and our pursuit of excellence in aesthetic medicine.
Medical Expertise × Aesthetic Taste
Led by a professional team from the National Taiwan University medical system, NAISS creates a space that is more than just aesthetic medicine — it’s a refined lifestyle. From consultation rooms to every treatment conversation, we care about every detail, crafting your unique radiance, starting with NAISS.

Meticulous Craftsmanship × Transformative Breakthroughs
Committed to top-tier service, we create a holistic experience of beauty.


Personalized
Planning
Prestige
Experience
Comprehensive
Aesthetics
Natural
Aesthetics

Professional
Led by NTU doctors with advanced equipment, offering tailored, science-based treatments.

Refined Quality
Premium ingredients and serene design deliver both beauty and effectiveness.

Delicacy
Thoughtful skincare and calming details turn each session into a wellness ritual.

Professional
Led by NTU doctors with advanced equipment, offering tailored, science-based treatments.

Refined Quality
Premium ingredients and serene design deliver both beauty and effectiveness.
Delicacy
Thoughtful skincare and calming details turn each session into a wellness ritual.

We believe, true beauty,
begins with refined detail

Branch Information
NAISS Clinic | Dunhua Branch
9F, No. 221, Sec. 4, Zhongxiao E. Rd., Da’an Dist., Taipei City (Huaxin Building)
Getting here: Exit 2, Zhongxiao Dunhua MRT Station, walk 80 meters straight
Mon, Wed–Fri: 12:00–22:00
|
Tue & Sat: 11:00–21:00
|
Closed on Sundays

Getting Here
